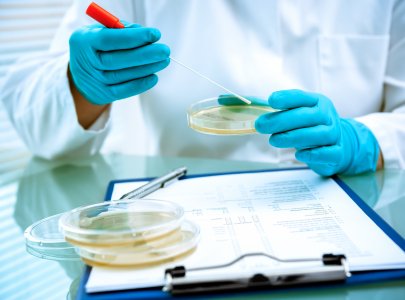
Call for Abstracts Increased Using LinkedIn for a Scientific Meeting

There’s no one-size-fits-all approach to association marketing and communications, so associations need to look beyond the typical agency for effective strategies.
As the in-house marketing and communications agency of an association management company, AH’s MarCom Department is uniquely positioned to strengthen relationships with members and communities, elevate brands, and deliver the most effective customized strategies for associations.
AH’s MarCom Department staffs experts in marketing, design, branding, content development, publishing, digital marketing, video, and public relations, allowing us to offer a diverse range of the latest marketing and communications solutions. We bring together our team of experts to develop customized strategies for your association that will drive growth and lead you toward your goals.